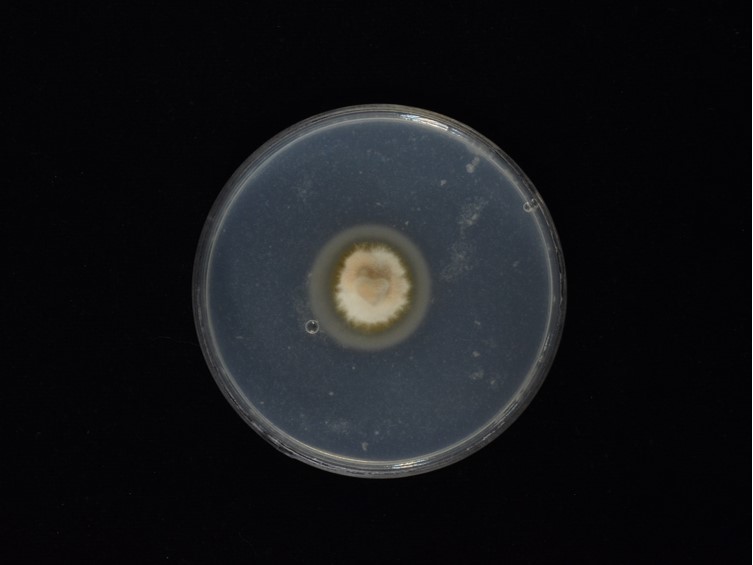

Holotype:
THAILAND, Nakhon Ratchasima Province, Khao Yai National Park, 1 Oct. 2014, S. Mongkolsamrit, A. Khonsanit, W. Noisripoom, D. Thanakitpipattana, R. Somnuk, holotype BBH 39608, ex-type living culture BCC 75694.
Habitat:
Underside of leaves.
Host:
Gryllidae.
Description:
Stromata multiple, arising from the head region and body of the insect host, pale cream, cylindrical, up to 8 mm long. Densely packed  perithecia occur in the middle of stromata, pale cream , ca 3 mm long. Perithecia superficial, ovoid, 180-250 × 140-200 µm.
perithecia occur in the middle of stromata, pale cream , ca 3 mm long. Perithecia superficial, ovoid, 180-250 × 140-200 µm.  Asci cylindrical, 8-spored, up to 125 µm long, 10-15 µm wide. Ascus-cap rounded, 5 × 5 µm.
Asci cylindrical, 8-spored, up to 125 µm long, 10-15 µm wide. Ascus-cap rounded, 5 × 5 µm.  Ascospores whole, filiform, hyaline, spirally arranged inside the ascus, aseptate, 45-90 × 2-2.5 µm. Asexual morph: Numerous synnemata growing from all over the host body. Occasionally hymenostilbe-like asexual morph is produced on the apex of the
Ascospores whole, filiform, hyaline, spirally arranged inside the ascus, aseptate, 45-90 × 2-2.5 µm. Asexual morph: Numerous synnemata growing from all over the host body. Occasionally hymenostilbe-like asexual morph is produced on the apex of the  stroma and below the perithecial layer. Numerous synnemata arising from the body and legs of the host producing hymenostilbe-like asexual morph. The synnemata measured up to 1 cm long and ca 0.5 mm wide, powdery due to sporulation, pale cream. Conidiophores arising from hyphae of synnemata, forming a hymenial layer. Phialides, 6-15 × 3-5 µm, hymenostilbe-like, clavate, cylindrical basal parts, bearing mini cylindrical projections, ca 1 × 0.5 µm. Conidia hyaline, smoothwalled, narrow fusoid, 1-celled, 5-8 × 1-2 µm.
stroma and below the perithecial layer. Numerous synnemata arising from the body and legs of the host producing hymenostilbe-like asexual morph. The synnemata measured up to 1 cm long and ca 0.5 mm wide, powdery due to sporulation, pale cream. Conidiophores arising from hyphae of synnemata, forming a hymenial layer. Phialides, 6-15 × 3-5 µm, hymenostilbe-like, clavate, cylindrical basal parts, bearing mini cylindrical projections, ca 1 × 0.5 µm. Conidia hyaline, smoothwalled, narrow fusoid, 1-celled, 5-8 × 1-2 µm.
Culture characteristics:
Colony on PDA slow-growing, attaining ca 0.8 cm diam after 21 d at 20 °C. Colony pink greyish, cottony with high mycelial density, brown pigment around the colony. Colony reverse pale brown. Vegetative hyphae smooth, septate, hyaline, 2–3 µm diam. Conidiogenous structures consisting of erect conidiophores arising from the vegetative hyphae. Conidiophores consist of verticillate
Colony on PDA slow-growing, attaining ca 0.8 cm diam after 21 d at 20 °C. Colony pink greyish, cottony with high mycelial density, brown pigment around the colony. Colony reverse pale brown. Vegetative hyphae smooth, septate, hyaline, 2–3 µm diam. Conidiogenous structures consisting of erect conidiophores arising from the vegetative hyphae. Conidiophores consist of verticillate  phialides, singly or in whorls of two to five. Phialides awl-shaped, acremonium-like, smooth-walled, 18–50 × 2–5 µm, bearing numerous lateral necks along the main phialide, 2–10 × 1 µm.
phialides, singly or in whorls of two to five. Phialides awl-shaped, acremonium-like, smooth-walled, 18–50 × 2–5 µm, bearing numerous lateral necks along the main phialide, 2–10 × 1 µm.  Conidia hyaline, ellipsoidal or reniform, 1-celled, 4–8 × 1.5–3 µm, aggregated in slimy heads. Chlamydospores not observed.
Conidia hyaline, ellipsoidal or reniform, 1-celled, 4–8 × 1.5–3 µm, aggregated in slimy heads. Chlamydospores not observed.
Reference:
Thanakitpipattana D, Tasanathai K, Mongkolsamrit S, et al. (2020). Fungal pathogens occurring on Orthopterida in Thailand. Persoonia 44: 140–160.
DOI: https://doi.org/10.3767/persoonia.2020.44.06Species |
Strain |
Compound |
Pubchem CID |
Biological activity |
Reference |
|---|
|
Strain |
|---|